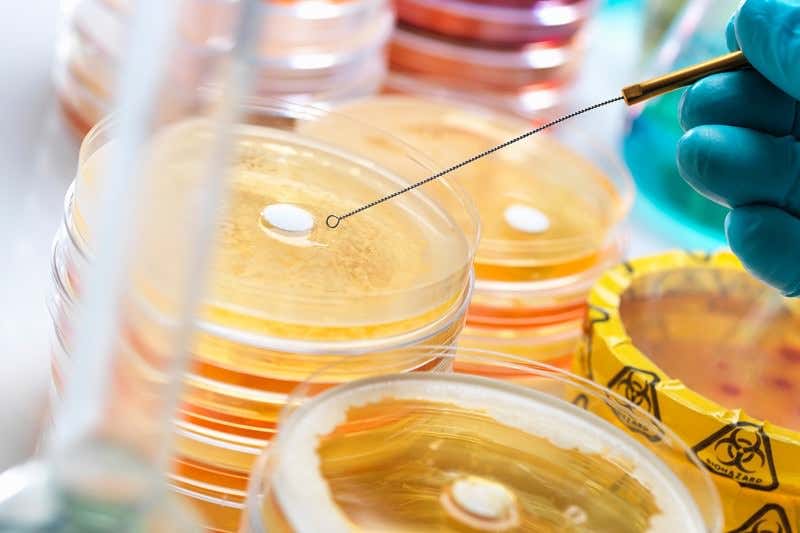
New Scientist. Science news and long reads from expert journalists, covering developments in science, technology, health and the environment on the website and the magazine.

Make it so they can’t resist (Image: Rafe Swan/Cultura/Getty)
A panel on antibiotics set up by the UK government says the world needs a global authority to pay drug companies to develop new antibacterial drugs. The panel predicts that spending between $16 billion and $37 billion this way over 10 years will lead to 15 new antibiotics. This includes four entirely novel types that do not fit into existing classes of antibiotics and will kill infections that now resist all drugs.
The cash figure may seem high, but the panel argues it is about what antibiotic-resistant bacteria already cost the healthcare system every year in the US alone. The panel calls on big pharma to “look beyond short-term assessments of profit and loss, and act with enlightened self-interest” in helping to fund the basic research that will allow the scheme to proceed.
The same expert committee, chaired by economist Jim O’Neill, formerly of investment bank Goldman Sachs, reported earlier this year that companies are not developing new antibiotics fast enough to keep up with the rate at which bacteria are becoming resistant to existing ones. In a report released last week it revealed that, out of 41 antibiotics in development worldwide, only three can kill more than 90 per cent of strains defined as public health concerns, which also covers five hard to kill “gram negative” bacteria including E. coli. None of those three has passed tests in people yet.
Advertisement
Radical delinkage
The problem, they explain, is that there is little profit in antibiotics. They must be used sparingly so as not to promote resistance. And a new antibiotic cannot compete with older drugs that are off-patent and therefore cheap, until bacterial resistance makes the old drugs useless. By then, the new drug is often near the end of its patent life, and profits from sales may not be enough to recoup its development costs.
The drug may then be oversold – especially in some developing countries where sales are poorly controlled – which results in soaring levels of resistance. “Regulation is not capable of curtailing overselling as long as pharmaceutical companies have a clear incentive to oversell their products,” says the report.
One proposed solution is to “delink” profits from sales. This week the committee proposed “the most radical means of implementing delinkage”: a global authority that would award lump sums to companies for bringing an antibiotic to market, then control its sales.
They estimate that between $2 billion and $3 billion would buy all the marketing rights to an antibiotic, which could then be carefully sold in the interests of public health, not profit. Alternatively, they suggest spending less, around $1 billion, for a less radical change in marketing: the global authority would have a say in how the drug was sold, but the company that developed it could still sell it for a profit.
Basic research boost
The committee says the more market-friendly solution seems more likely to get support from governments. “They will have to set clear sales guidelines, especially on advertising” for it to work, says John-Arne Røttingen of the Norwegian Institute of Public Health.
Lump-sum payments once a drug has reached the market might not be enough to guarantee success, however. The scheme resembles another effort to promote otherwise unprofitable pharmaceutical R&D, the US BioShield Programme for anti-bioterrorism drugs. The venture failed – partly because small, innovative companies couldn’t afford years of testing to get a drug to market, for an uncertain pay-off at the end if the drug actually worked. “Other incentives may be needed,” says Røttingen.
But the plan would be good news for basic research. O’Neill’s team calls for $2 billion over five years for blue-sky research into antibiotics and other antibacterial measures such as diagnostics and vaccines. “This would be a very significant increase over existing funding levels,” says Kevin Outterson of Boston University, who helped brief the committee.
The committee hopes big pharma will pay for this research scheme, as it has a “commercial imperative to having effective antibiotics, as well as a moral one”. One example: cancer drugs are very profitable, but treating cancer is impossible unless doctors also have antibiotics that work, because some treatments supress the immune system, leaving patients vulnerable to infections.
Topics:



